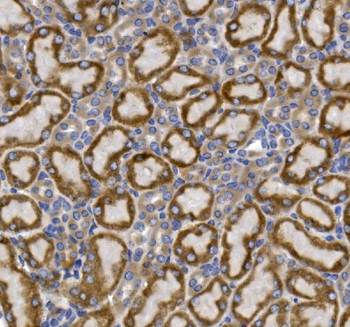
GLUT9/SLC2A9 Rabbit Polyclonal Antibody

You have no items in your shopping cart.
All Products
- NFIC/CTF Rabbit Polyclonal Antibody [orb654354]
ELISA, FC, IF, IHC, WB
Human, Mouse, Rat
Rabbit
Polyclonal
Unconjugated
100 μg - NOVA2 Rabbit Polyclonal Antibody [orb654356]
ELISA, FC, IHC, WB
Human, Mouse, Rat
Rabbit
Polyclonal
Unconjugated
100 μg ELISA, FC, ICC, IF, IHC, WB
Human, Monkey, Mouse, Rat
Rabbit
Polyclonal
Unconjugated
100 μg- GLUT9/SLC2A9 Rabbit Polyclonal Antibody [orb623823]
ELISA, FC, ICC, IF, IHC, WB
Human
Rabbit
Polyclonal
Unconjugated
100 μg - Angiopoietin-2/ANGPT2 Rabbit Polyclonal Antibody [orb623786]
ELISA, FC, ICC, IF, IHC, WB
Human, Mouse, Rat
Rabbit
Polyclonal
Unconjugated
100 μg - Menin/MEN1 Rabbit Polyclonal Antibody [orb623872]
ELISA, IHC, WB
Human, Mouse, Rat
Rabbit
Polyclonal
Unconjugated
100 μg - Mannose Receptor/MRC1 Rabbit Polyclonal Antibody [orb623873]
ELISA, IF, IHC, WB
Human, Monkey, Mouse, Rat
Rabbit
Polyclonal
Unconjugated
100 μg - MTA2/PID Rabbit Polyclonal Antibody [orb623875]
ELISA, FC, ICC, IF, IHC, WB
Human, Mouse, Rat
Rabbit
Polyclonal
Unconjugated
100 μg - XLF/NHEJ1 Rabbit Polyclonal Antibody [orb623876]
ELISA, FC, ICC, IF, IHC, WB
Human, Mouse
Rabbit
Polyclonal
Unconjugated
100 μg - Hexokinase 1/HK1 Mouse Monoclonal Antibody [orb654273]
FC, ICC, IF, IHC, IHC-Fr, WB
Human, Mouse, Rat
Mouse
Monoclonal
Unconjugated
100 μg